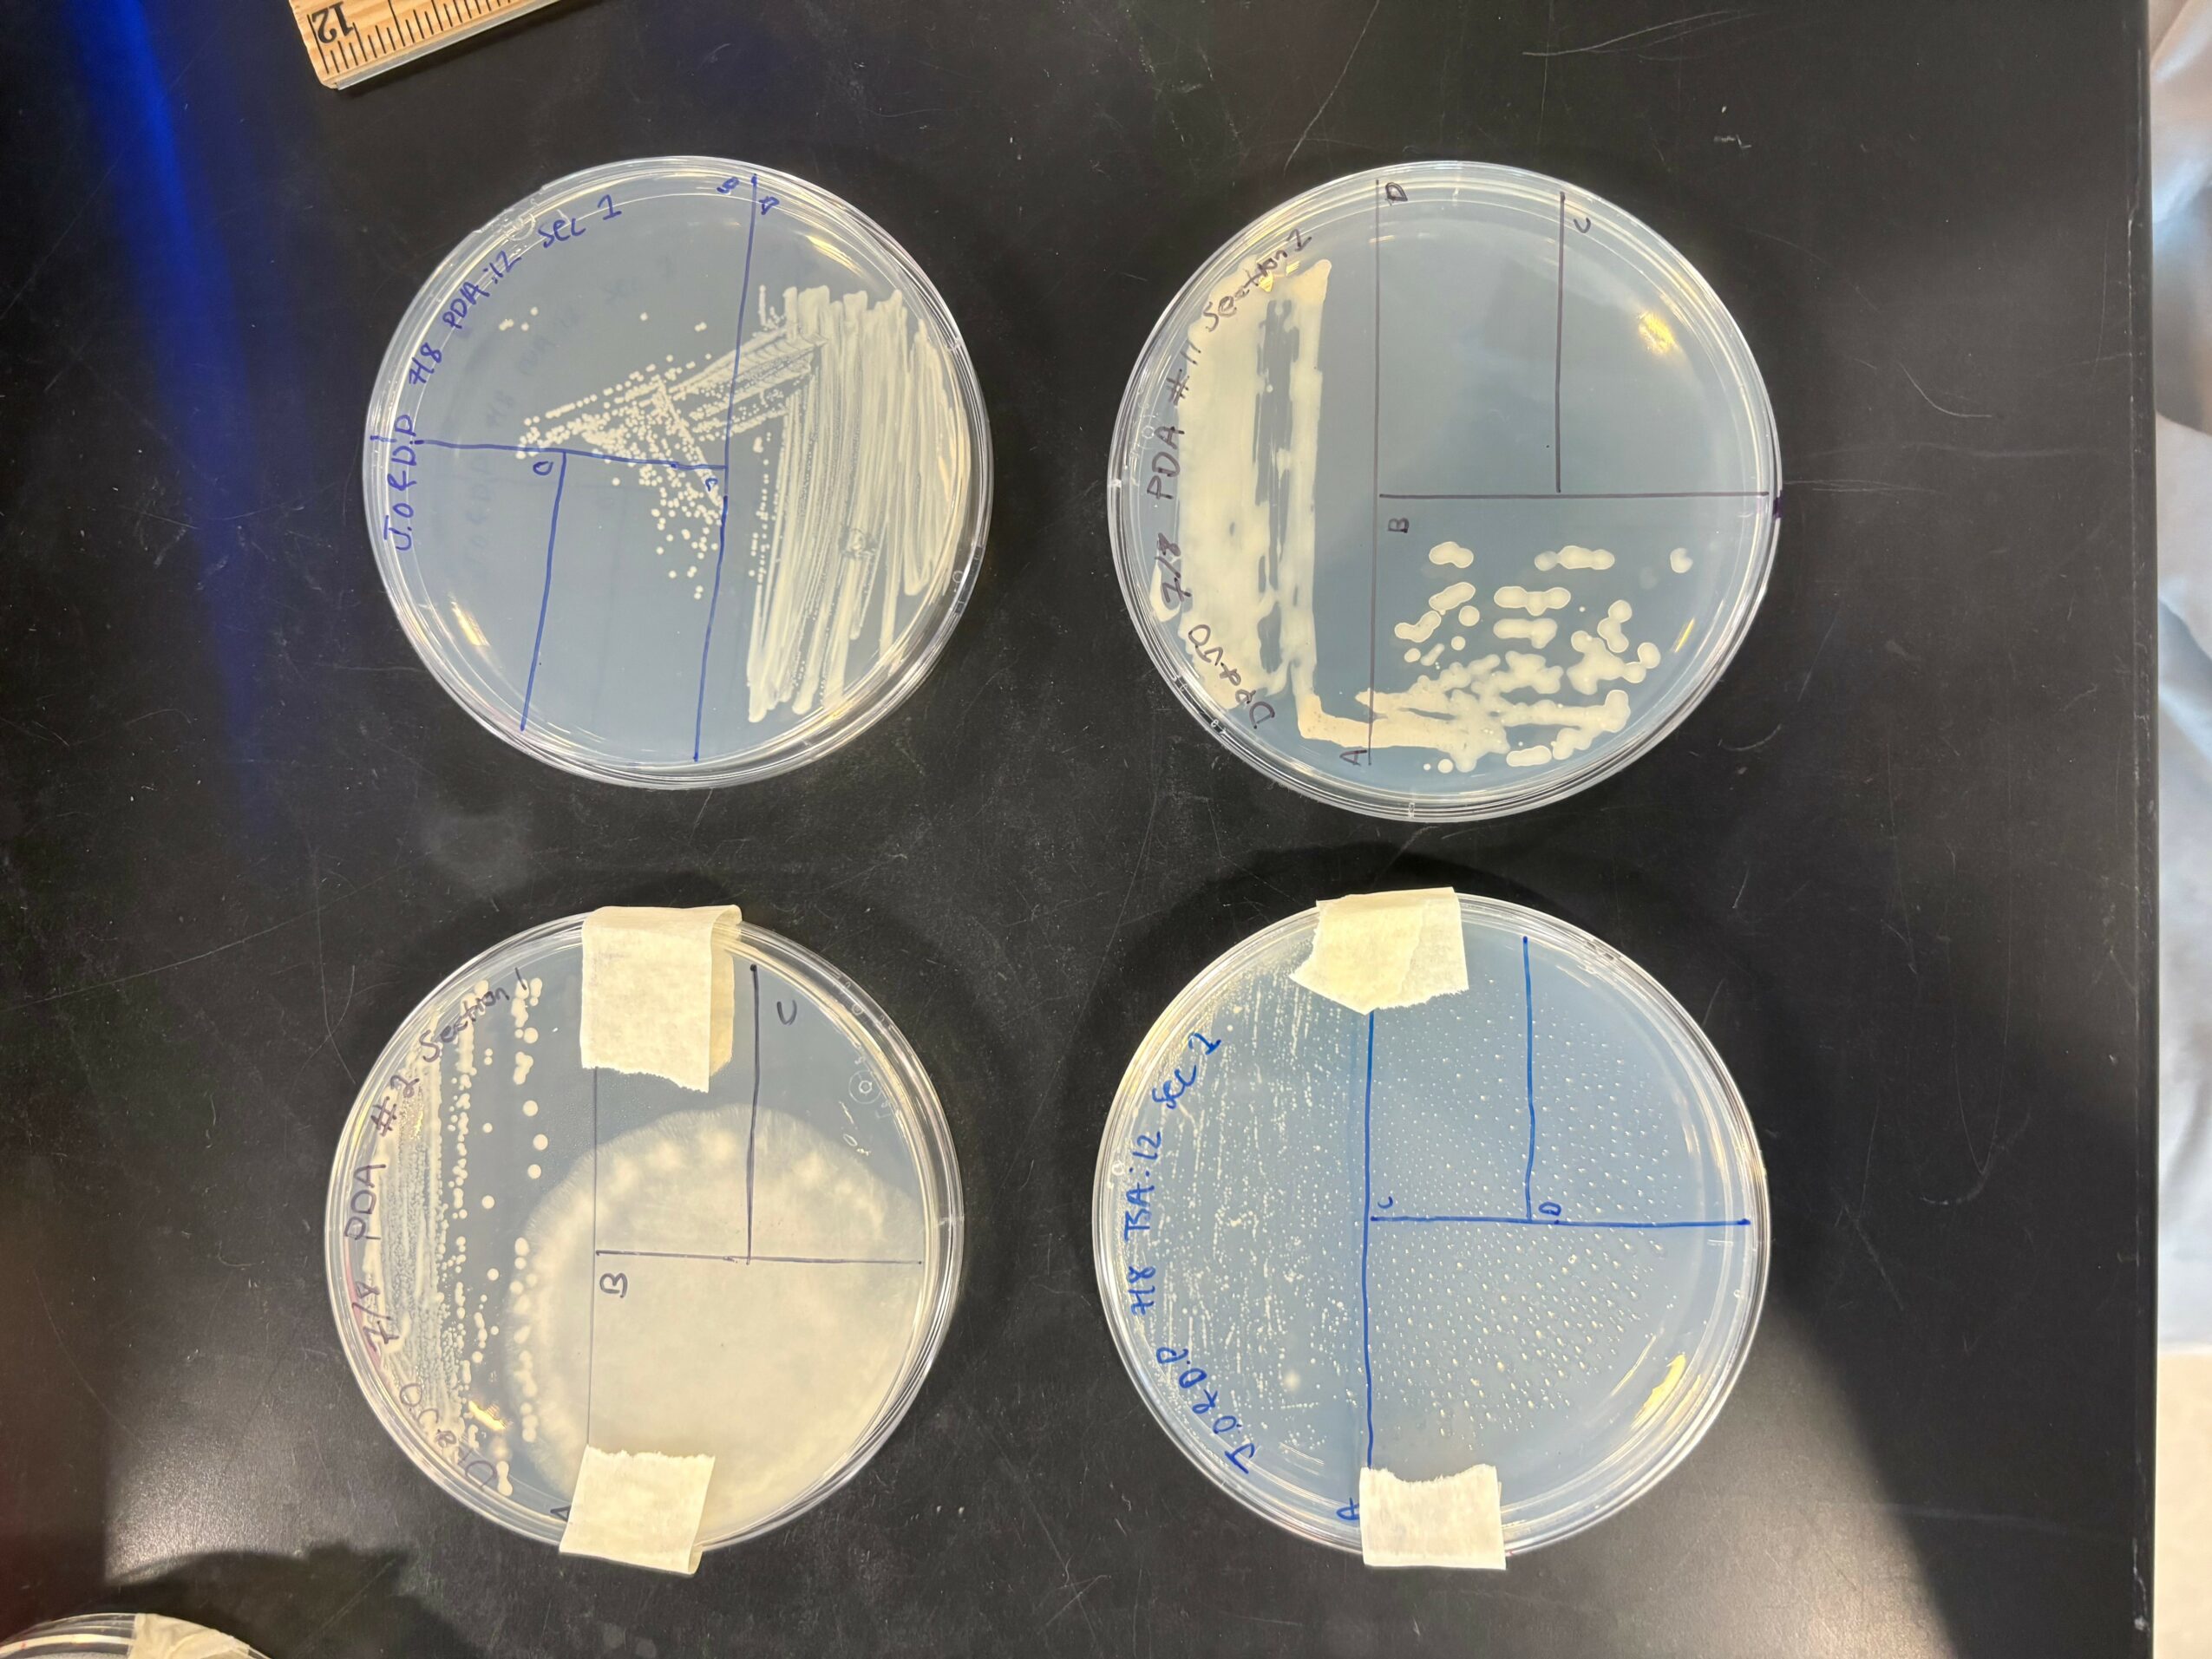

We’re looking forward to introducing you to Jennifer Odikpo. Check out our conversation below.
Jennifer, really appreciate you sharing your stories and insights with us. The world would have so much more understanding and empathy if we all were a bit more open about our stories and how they have helped shaped our journey and worldview. Let’s jump in with a fun one: What battle are you avoiding?
The ignorance is bliss phrase is unfortunate yet easy. As someone who was quick to graduate early for the advancement of her academic career, I too have been ignorant. I was quick to delay my career choice, and quick to undermine myself when I made simple mistakes. Although I wasn’t aware deep down, I was willfully ignorant to what lied ahead for me if I kept denying my truths. I was or I unintentionally try to avoid adulthood where I would no longer have grace in my decisions because I would be “old enough to understand.”
Can you briefly introduce yourself and share what makes you or your brand unique?
I’m a beauty and lifestyle content creator based out in Dallas. I currently work for Sephora where you’ll see me shade-matching my clients around the store or speed walking to go get a fragrance from the back. As a Nigerian American from Texas, my expectations to succeed are farther than you could fathom. Although my creativity knows no bounds, with how I tie my marketing hobby into my pre-med regimen. I go to school hoping for med school and happiness in life, and for stability in my future.
Okay, so here’s a deep one: Who taught you the most about work?
My dad definitely taught me the most about work. From searching up the highest paid salaries on the family
computer, to taking trips to fancy mansions on late night drives, he steered the way I thought about what I should study and how I’ll be successful doing what’s true to
myself and for my future.
When you were sad or scared as a child, what helped?
I have this stuffed koala I modeled after Cameron Boyce’s koala kenny he had on the show Jessie. I got it shortly after he and my grandma died the same month, and it’s been able to comfort me at night ever since.
Next, maybe we can discuss some of your foundational philosophies and views? What are the biggest lies your industry tells itself?
The medical industry exploits nurses to the point of exhaustion, and there’s this food chains in hospitals. It puts nurses on the bottom in terms of respect although they know the ins and outs of everything, and they do alot of heavy lifting. The lie is that doctors take the bulk of the work and deserve the most respect, which is true they got the medical degree. Although, patients see their nurses more do doctors and so on.
Okay, so before we go, let’s tackle one more area. If you knew you had 10 years left, what would you stop doing immediately?
Procrastination. It’s one hell of a drug fueled from this inflation of people thinking they have all the time in the world. I’m no different and I would make haste the moment I learned that.
Contact Info:
- Website: https://beacons.ai/jennipoppi
- Instagram: https://www.instagram.com/jennipoppy
- Linkedin: https://www.linkedin.com/in/jennifer-odikpo-ba9499249?utm_source=share&utm_campaign=share_via&utm_content=profile&utm_medium=ios_app
- Youtube: https://www.youtube.com/jennipoppi
- Other: tiktok: https://www.tiktok.com/@jennipoppi